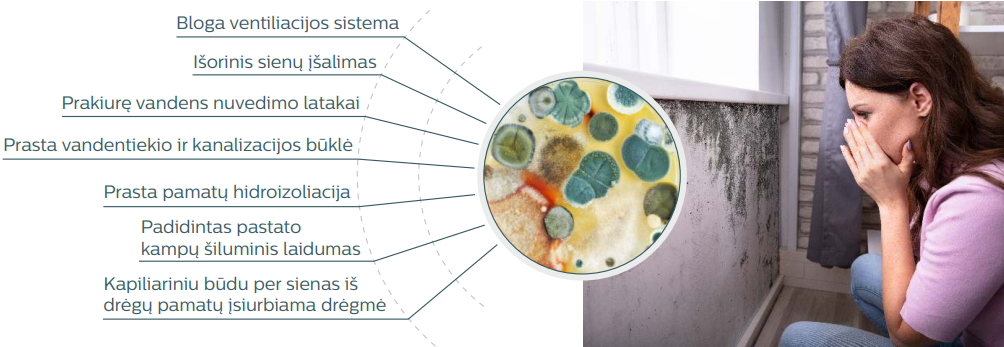
Pelesio naikinimas

Pelėsio naikinimas
Pelėsio naikinimas patalpose
Laboratoriniais tyrimais nustatoma pelėsių sporų koncentracija komercinių, prekybos, maitinimo, paslaugų teikimo ir kt. patalpų ore;
Pašalinamas pelėsis ir jo atsiradimo priežastys;
Sertifikuotais prietaisais nustatomas rasos taškas ir santykinė patalpų oro drėgmė;
Naikinamas pelėsis giluminiuose pastato konstrukcijose ir apdailos sluoksniuose;
Teikiamos rekomendacijos pelėsio atsiradimo darbo patalpose prevencijai;
Sertifikuotu ozonatoriumi ir/arba jonizatoriumi naikinamas pelėsis esantis komercinių, prekybos ar kitų paslaugų teikimo patalpų ore ir šalinami visų patalpų pašaliniai kvapai.
Kaip atpažinti, kad pas jus apsigyveno pelėsis
Patalpų paviršių pamėlynavimas, pažaliavimas, sienų lupimasis, juodi taškeliai ant lubų, nemalonus kvapas rodo, kad pas jus apsigyveno pelėsis. Pelėsinių grybelių kolonijos būna skirtingų spalvų, pavyzdžiui, Alternaria ir Aspergillus niger – juodos arba rudos, Penicillium – mėlynos arba žalios. Pelėsiai taip pat gali būti pilkos, geltonos ir raudonos spalvos.
Pelėsio atsiradimo priežastys
Žmonėms, dažniausiai dėl nežinojimo, rūpi tik estetinė pelėsio pusė. Juodos arba pilkos spalvos dėmės atrodo kaip nešvarumai, o atsiradęs nemalonus patalpos kvapas siejamas su nepakankamu vėdinimu. Dauguma net neįtaria, kad namuose užsiveisė sveikatai pavojingi pelėsiai, o nemalonus kvapas, tai pelėsio išskirti lakieji junginiai, galintys sukelti rimtas sveikatos problemas.
Kadangi pelėsio sporos sklando ore, pelėsio kenksmingas poveikis apima daug didesnį plotą, nei tą, kuriame židinys vizualiai matomas. Būdami namuose, net jei pelėsis yra tik namo rūsyje, rizikuojate įkvėpti jo oru sklandančių sporų.
Labiausiai nemalonu tai, kad daugelis ligų, kurias sukelia pelėsinių grybų sporos, yra sunkiai diagnozuojamos, todėl dažnai pacientų gydymas neveiksmingas.
Pelėsių sukeliamos ligos

Pelėsių poveikis gyvenamai aplinkai
Labai dažnai pelėsiai atsiranda patalpose, kuriose yra blogas vėdinimas, per didelis drėgmės kiekis. Jis gali gyventi beveik ant bet kokių paviršių.
Pasaulio sveikatos organizacijos (PSO) duomenimis, apie 30% visų pastatų turi vidaus patalpų oro kokybės problemų dėl patalpų drėgmės ir pelėsio.
Pelėsis kenkia ne tik fizinei sveikatai. Drėgmė pavojinga ir pastatui, nes ardo jo konstrukcijas, sienas.
Mediena, betonas, plytos, plastikai, galiausiai praranda savo savybes, sutrumpėja pastato eksploatacijos laikas. Užkrėstos medinės konstrukcijos gali suirti vos per keletą metų, nes medyje gyvenantis grybas išskiria fermentą, kuris ardo celiuliozę, medienos struktūros pagrindą.
Blogiausia, kad laikui bėgant pelėsiai ne tik nusėda ant medžiagos paviršiaus, bet ir prasiskverbia į jos vidų. Pelėsių hifai (siūleliai), apie 1 mikrono storio, panašūs į čiuptuvus, jie apgaubia pastato struktūrą ir prasiskverbia vis giliau. Jei sienos yra užkrėstos pelėsiu iš vidaus, su pelėsiu tampa labai sunku kovoti.
Pelėsių metaboliniai produktai turi chemiškai aktyvių mineralinių ir organinių rūgščių. Jie prasiskverbia į statybinių medžiagų paviršių mažiausiais kapiliarais ir palaipsniui juos sunaikina.
